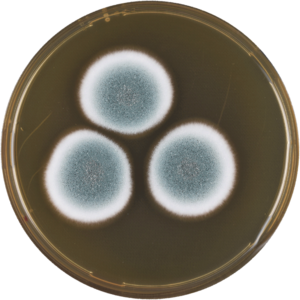

Aspergillus duricaulis الإنجليزية (Q5907331)
نوع من الفطريات
| اللغة | التسمية | الوصف | أسماء أخرى |
|---|---|---|---|
| العربية | لم تُضف التسمية |
نوع من الفطريات |
|
| الإنجليزية | Aspergillus duricaulis |
species of fungus |
بيانات
Wikidata item الإنجليزية
taxon name الإنجليزية
taxon rank الإنجليزية
instance of الإنجليزية
parent taxon الإنجليزية
Google Knowledge Graph ID الإنجليزية
image الإنجليزية
Aspergillus duricaulis meaox.png
٣٬٤٠٧ × ٣٬٤٠٧؛ ٤٫٤٤ ميجابايت
٣٬٤٠٧ × ٣٬٤٠٧؛ ٤٫٤٤ ميجابايت
١ مراجع
Imported from Wikidata item الإنجليزية
Commons category الإنجليزية
short name الإنجليزية